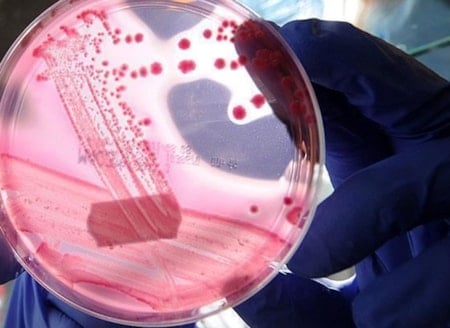
DSÖ'den kanser açıklaması: Dünya genelindeki vakaların 4'te 1'i önlenebilir

Kamuoyunda en çok "beyin yiyen amip" olarak bilinen Naegleria fowleri, burun yoluyla vücuda girdiğinde neredeyse her zaman ölümcül olmasıyla tanınıyor. Ancak uzmanlar, bu korkutucu örneğin buzdağının sadece görünen kısmı olduğuna dikkat çekiyor.
Amip türlerinin büyük bir kısmı zararsız kabul edilse de, yapılan araştırmalar bazı türlerin modern su sistemlerinde hayatta kalabilecek şekilde evrimleştiğini gösteriyor. Bu durum, güvenli olduğu varsayılan şehir şebekelerini bile potansiyel bir risk alanına dönüştürüyor.
Çin'deki Sun Yat-sen Üniversitesi'nden çalışmanın başyazarı Longfei Shu, bu organizmaların tehlikesini dayanıklılıklarına bağlıyor. Shu'ya göre bu canlılar, diğer birçok mikrobun yok olduğu koşullarda bile hayatta kalabiliyor.
Yüksek sıcaklıklara ve klor gibi güçlü dezenfektanlara karşı tolerans geliştiren amipler, insanların temiz olduğunu düşündüğü su şebekelerinde yaşamlarını sürdürebiliyor.
'TRUVA ATI' GİBİ DAVRANIYORLAR
Araştırmanın en endişe verici bulgularından biri ise amiplerin su sistemlerinde adeta birer "Truva Atı" gibi davranması. Bu tek hücreli canlılar, içlerinde zararlı bakteri ve virüsleri barındırarak onları dezenfeksiyon süreçlerinden koruyor.
Bu mekanizma sadece hastalıkların yayılmasına yol açmakla kalmıyor, aynı zamanda küresel bir sağlık sorunu olan antibiyotik direncinin de su şebekeleri aracılığıyla taşınmasına neden oluyor.

İklim değişikliğiyle birlikte artan su sıcaklıkları da bu patojenler için mükemmel üreme alanları yaratıyor. Isınan iklim, sıcak seven amip türlerinin coğrafi sınırlarını genişleterek, daha önce bu türlerin hiç görülmediği serin bölgelerde bile enfeksiyon vakalarının rastlanmasına yol açıyor.
Bilim insanları, giderek büyüyen bu sorunla mücadele etmek için insan sağlığı, çevre bilimi ve su yönetimini birleştiren koordineli bir "tek sağlık" (One Health) yaklaşımının benimsenmesi gerektiğini vurguluyor.
SciTechDaily'ye göre çözüm için önerilen adımlar arasında su sistemlerinde daha güçlü gözetim mekanizmaları, gelişmiş tanı araçları ve enfeksiyon riskini oluşmadan azaltacak ileri su arıtma teknolojilerinin kullanılması yer alıyor.